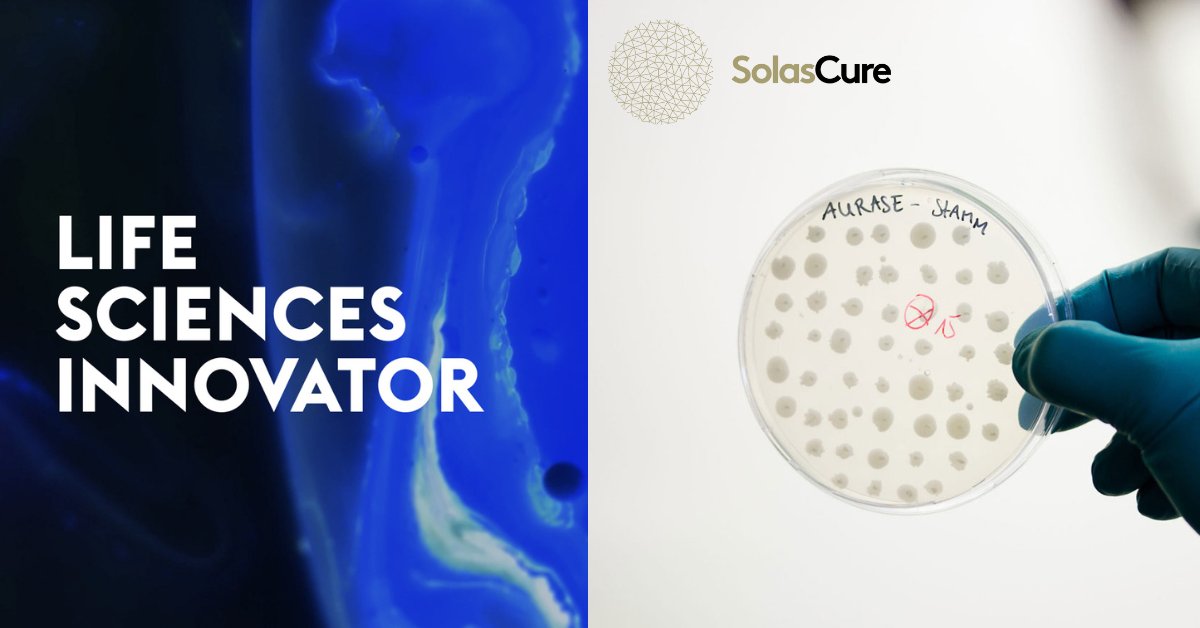
SolasCure are delighted to have been selected as a UK Life Sciences Innovator 2023. This is significant recognition by @tradegovukMEAP of our propriety technology as we work to develop revolutionary wound care treatments.

#LSI2023 #UKInnovation #LifeSciences #Future #Technology

SolasCure
@solascure
Revolutionising wound care with biomimicry and evidence-based medicine
ID: 1392421689116536833
12-05-2021 10:09:46
107 Tweet
62 Followers
194 Following









Meet Prof. DavidGoldsmith, Chief Medical Officer at SolasCure. Prof. Goldsmith is a former Emeritus Professor of Cardio-Renal Medicine at the University of London & former Consultant Nephrologist at Guy’s & St Thomas’ NHS Foundation Trust Hospital. solascure.com







SolasCure is delighted to announce that CTO Dr Bela Kelety will be speaking at this year’s Pharma Contract Manufacturing conference in Berlin from 28th -30th March, sharing insights on the importance of scaling up for start-ups. Pharmaceutical News #pharmaevents #PCM2023 #biotech






NEWS: SolasCure is delighted to announce that it has been selected to receive the European Innovation Council’s European Innovation Council Accelerator Grant to continue development of its innovative wound care technology. Read more: bit.ly/3FGZLnH #woundcare #chronicwounds #EIC